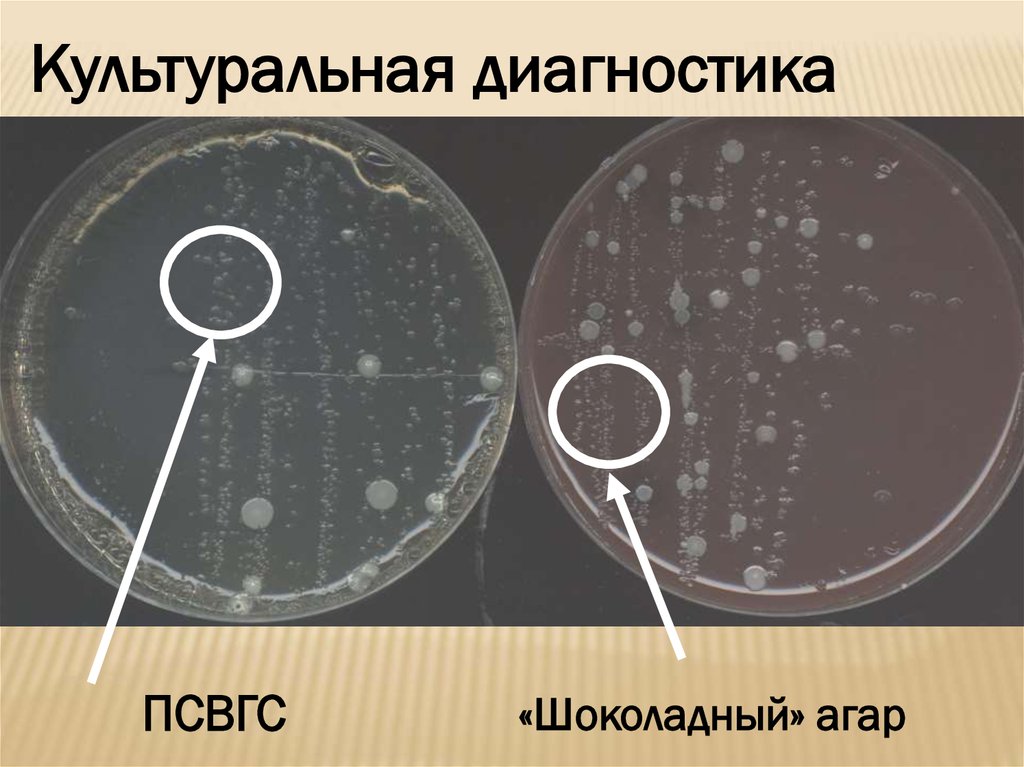

Похожие презентации:
Гонорея
1. Гонорея Выполнила: Студентка 5 курса 533 группы Тимошенко М. К.
Федеральное государственное бюджетное образовательное учреждение высшегообразования «Тюменский государственный медицинский университет»
Министерства здравоохранения Российской Федерации
(ФГБОУ ВО ТюмГМУ Минздрава России)
Кафедра кожных и венерических болезней
Заведующий кафедрой: д.м.н, доцент Матусевич С.Л.
Преподаватель:ассистент кафедры Быстрицкая О.Д.
ГОНОРЕЯ
ВЫПОЛНИЛА:
СТУДЕНТКА 5 КУРСА 533 ГРУППЫ
ТИМОШЕНКО М. К.
2.
Гонорея – это контагиозное инфекционноезаболевание, возбудителем которого является
гонококк (Neisseria gonorrhoeae).
3.
ЭтиологияВозбудитель – Neisseria gonorrhoeae
современное название болезни – гонорея – ввёл Гален;
возбудителя открыл Нейссер в 1879 г.;
этиологическую роль гонококка в развитии гонореи
доказал Бумм в 1885 г.
4.
Свойства гонококка• аэробы или факультативные анаэробы;
• быстро погибает вне человеческого организма;
• малоустойчив к внешним воздействиям:
* гибнет по мере высыхания;
* под влиянием УФО;
* при повышении температуры до 56оС;
* при воздействии солей ртути и серебра;
* при воздействии антисептиков.
5.
Свойства гонококка• размножение путём поперечного деления;
• при неблагоприятных условиях могут образовывать
L-формы;
• L-формы устойчивы к антибиотикам;
• возможна реверсия L-форм в исходные бактерии;
• некоторые гонококки имеют капсулоподобные
образования, что снижает эффективность фагоцитоза
(незавершённый фагоцитоз)
6.
ЭПИДЕМИОЛОГИЯ ГОНОРЕИПути заражения гонореей
• половой (преимущественный);
• перинатальный (в родах);
• тесные бытовые контакты
(характерно для маленьких детей)
7.
Источником инфекции является больнойчеловек или бактерионоситель
2
1,5
1
0,5
0
Мужчины
Женщины
Соотношение больных мужчин и женщин
1,5 : 2,0
8.
Риск заражения здорового мужчины отбольной гонореей женщины при
однократном незащищённом половом
контакте составляет в среднем 25%.
90
80
80
70
%
60
60
50
40
30
20
10
0
25
9.
Ассоциация гонококковой инфекции сдругими ИППП (хламидиоз, трихомониаз)
В настоящее
время
в 29 – 80%
случаев
10.
ПАТОГЕНЕЗ ГОНОКОККОВОЙ ИНФЕКЦИИ• излюбленная локализация –
кубический и цилиндрический эпителий;
• возможно поражение
многослойного плоского
эпителия (у девочек);
1-я стадия – адгезия гонококков при
помощи пилей на мембране
эпителиальной клетки
11.
ПАТОГЕНЕЗ ГОНОКОККОВОЙ ИНФЕКЦИИВыход гонококков в
субэпителиальное
пространство
сопровождается
гибелью эпителиоцитов
+
выраженная реакция
нейтрофилов
приводит к образованию подслизистых
микроабсцессов и экссудации гноя
12.
ПЯН –полиморфно
ядерные
нейтрофилы
ЛПС –
липополисахарид
ТНФ –
фактор
некротизации
опухоли
13.
Микрофотография фаллопиевой трубы через 20 чпосле заражения Neisseria gonorrhoeae
14.
Электронные микрофотографии взаимодействия лимфоцита и N. gonorrhoeaeDr. Ian Boulton, Nat Immunol. 2002 3:229-236
15.
В среднем, весь процесс от моментапопадания гонококка
на слизистую оболочку до
возникновения воспалительной
реакции в подслизистом слое занимает 3-4 дня
Инкубационный период
Сроки инкубационного периода могут
сильно варьировать: от 2 дней до 1 месяца
16. Патогенез
ПАТОГЕНЕЗГонококки поражают органы, слизистые
оболочки которых покрыты цилиндрическим
эпителием
- уретра
- конъюнктива глаз
- цервикальный канал
- нижняя часть прямой кишки
- крайне редко в процесс вовлекаются
многослойный плоский эпителий наружные
гениталии и глотка
Синовиальная оболочка суставов
17. Классификация гонореи
КЛАССИФИКАЦИЯ ГОНОРЕИПо давности заболевания
1. Свежая гонорея – давность до 2 месяцев
- острая
- подострая
- торпидная
2. хроническая гонорея – давность более 2
месяцев
3. Латентная гонорея
18. Клиника
КЛИНИКАИнкубационный период - от
1 дня до двух месяцев
(обычно 2-3 дня)
Клиника гонореи у мужчин
Определяется в виде
поражения патологическим
процессом
мочеиспускательного канала,
а другие проявления
рассматриваются как
осложнения уретрита
19. Свежий острый гонорейный уретрит
СВЕЖИЙ ОСТРЫЙ ГОНОРЕЙНЫЙ УРЕТРИТЖалобы на:
- боли, рези при мочеиспускании;
- обильные желтовато-зеленые выделения из уретры;
- губки уретры гиперемированны, отечны;
- при пальпации уретры – болезненность, инфильтрация
Проба Томпсона
Двухстаканная проба, для определения глубины
поражения уретры:
Моча в первой порции мутная а во второй прозрачная – передний
уретрит
Моча во всех порциях мутная, хлопья – тотальный или задний
уретрит
20. Свежий подострый гонорейный уретрит
СВЕЖИЙ ПОДОСТРЫЙ ГОНОРЕЙНЫЙ УРЕТРИТ21.
КЛИНИКА ГОНОКОККОВОЙ ИНФЕКЦИИОстрый передний уретрит
22.
23.
24.
25. Свежий торпидный гонорейный уретрит
СВЕЖИЙ ТОРПИДНЫЙ ГОНОРЕЙНЫЙ УРЕТРИТЖалобы на:
- незначительные боли и рези при мочеиспускании;
- скудные выделения из уретры;
- губки уретры иктеричны;
Проба Томпсона
Двухстаканная проба, для определения глубины
поражения уретры:
Моча в первой порции опалесцирует или прозрачная единичные
гнойные нити, хлопья
26. Хронический гонорейный уретрит
ХРОНИЧЕСКИЙ ГОНОРЕЙНЫЙ УРЕТРИТХарактерно хроническое течение с
периодическими обострениями напоминающими
по клинике острый и подострый процесс;
- субъективные ощущения отсутствуют или
слабовыраженны;
- склеивание наружного отверстия уретры;
- скудные серозно-гнойные выделения после
длительной задержки мочи;
- моча в двух стаканах мутноватая или
прозрачная, единичные хлопья, нити
27. Уретроскопия
УРЕТРОСКОПИЯЭрозии – разрыхление, дистрофия, десквамация
эпителиальных клеток;
Лейкоплакии – пролиферация клеток;
Мягкий инфильтрат – слизистая гиперемированна,
отёчна;
Твердый инфильтрат – слизистая серовато-белая, сухая;
Стриктуры;
Грануляции;
Литреит,
Морганьит;
Бляшки “Перьина”
28. Осложнения гонореи у мужчин
ОСЛОЖНЕНИЯ ГОНОРЕИ У МУЖЧИН- воспаление внутреннего листка крайней плоти – постит;
- воспаление кожи головки полового члена – баланит;
-воспаление семенного пузырька – колликулит;
- поражения кожи;
- тизонит;
- парауретрит;
-литреит, лакунит;
-лимфангит, лимфоаденит;
-куперит;
-эпидидимит;
-простатит;
-везикулит;
- стриктуры уретры;
-импотенция;
-бесплодие
29. Клиника гонореи у женщин
КЛИНИКА ГОНОРЕИ У ЖЕНЩИНГонорея нижнего отдела мочеполовых органов
- уретрит
- парауретрит
- вульвит
- бартолинит
- вагинит
- эндоцервицит
30. Клиника гонореи у женщин
КЛИНИКА ГОНОРЕИ У ЖЕНЩИНВосходящая гонорея
- эндометрит
- сальпингит
- оофорит
- аднексит (сальпингоофорит)
- пельвиоперитонит
- гонококковая септицемия
- гонококковая септикопиемия
31. Гонорея новорожденных
ГОНОРЕЯ НОВОРОЖДЕННЫХПри заражении при родах в первую очередь
страдает конъюнктивальный мешок глаз, в этом
случае развивается заболевание под названием
гонобленнорея — острый гонококковый
конъюнктивит. Для профилактики этой патологии
всем новорожденным производят закапывание
глаз 30% альбуцидом. Однако при родах вне
лечебного учреждения или же в том случае, если
беременная женщина не состояла на учете в
женской консультации и больна гонореей,
заражение младенцев все же возможно.
32.
Гонобленнорея обычно поражает оба глаза одновременно и безлечения в большом проценте случаев приводит к слепоте.
Симптомы конъюнктивита развиваются через несколько дней от
момента рождения ребенка и проявляются в виде припухлости и
гиперемии век. Появляется вначале скудное, затем обильное
гнойное отделяемое, глаза слипаются, что делает невозможным
открыть веки для осмотра. Гонококки проникают в более глубокие
ткани глазного яблока, затрагивая роговую оболочку, что в итоге
приводит к бельму и резкому снижению зрения.
У девочек помимо конъюнктивы глаз при родах может
инфицироваться и влагалище. Особенно легко это происходит при
ягодичном предлежании плода. Поэтому всем новорожденным
девочкам помимо глаз закапывают несколько капель альбуцида и в
половую щель.
33.
34.
35. Гонобленорея
ГОНОБЛЕНОРЕЯ36. Диагностика гонореи
ДИАГНОСТИКА ГОНОРЕИМужчины – отделяемое из уретры,
предварительно очистив ее отверстие
тампоном смоченным изотоническим
раствором
Женщины – выделения из уретры, шейки
матки, заднего свода влагалища, прямой кишки
При обследовании на фарингеальную гонорею
стерильным ватным тампоном из лакун
миндалин и задней глотки
37.
Принципиальная схема лабораторной диагностики гонореиОтделяемое из уретры, шейки матки, прямой кишки, ротоглотки, глаз, секрет предстательной железы
Бактериоскопия
(окраска 1%
метиленовым синим;
окраска по Граму)
ПЦР,
ЛЦР
Отделяемое из шейки матки,
прямой кишки, ротоглотки,
глаз
Отделяемое из шейки матки,
уретры, секрет простаты
Бактериологичекое
исследование
Грам-отрицательные
внутриклеточные диплококки
Селективные среды
(Thayer-Martin,
New-York City,
GonoLine)
Неселективные среды
(«шоколадный агар»,
ГНК-агар, ПСВГС)
Инкубация в СО2-термостате
Рост характерных колоний
Бактериоскопия
(окраска по Граму)
Грам-отрицательные
внутриклеточные
диплококки
Микробиологические
тесты:
оксидазный,
супероксольный,
утилизация углеводов
(гонококки избирательно
ферментируют
только глюкозу)
Продукция -лактамаз
(нитроцефиновый тест)
Определение чувствительности
к антибиотикам (E-test,
диско-диффузионный метод,
метод разведения в агаре)
38.
ДИАГНОСТИКА ГОНОРЕИМИКРОСКОПИЯ
Окраска по Граму
Внутриклеточные диплококки
39.
ДИАГНОСТИКА ГОНОРЕИМИКРОСКОПИЯ
Окраска по Граму
40.
Культуральная диагностикаПСВГС
«Шоколадный» агар
41.
Супероксольный тест42.
Оксидазный тест43.
СГМА44.
Факторы распространенияантибиотикоустойчивых N. gonorrhoeae
Не контролируемые
Контролируемые
• бессимптомные формы
• неадекватное лечение;
инфекции;
• инкубационный период;
• поведенческие
особенности;
• путешествия
• безрецептурный отпуск АБ;
• отсутствие программ по
контролю за ИППП;
• недостаточность бактериологической диагностики
45.
46.
Рекомендации по выбору АБП для лечениягонококковой инфекции
ЛЕЧЕНИЕ ГОНОРЕИ НИЖНИХ
ОТДЕЛОВ МОЧЕПОЛОВОГО
ТРАКТА БЕЗ ОСЛОЖНЕНИЙ
Рекомендуемые схемы:
• Цефтриаксон – в/м 250 мг
однократно
• Ципрофлоксацин - 500 мг
внутрь однократно
Альтернативные схемы:
• Офлоксацин - 400 мг внутрь однократно
• Спектиномицин - 2,0 г в/м однократно
• Цефодизим - в/м 500 мг однократно.
47.
ЛЕЧЕНИЕ ГОНОРЕИ НИЖНИХ ОТДЕЛОВМОЧЕПОЛОВОГО ТРАКТА С ОСЛОЖНЕНИЯМИ,
ГОНОРЕИ ВЕРХНИХ ОТДЕЛОВ
И ОРГАНОВ МАЛОГО ТАЗА,
ДИССЕМИНИРОВАННОЙ ГОНОКОККОВОЙ
ИНФЕКЦИИ (ДГИ)
Рекомендуемая схема:
Цефтриаксон - 1,0 г в/м или в/в
каждые 24 часа.
Альтернативные схемы:
Цефотаксим - 1,0 г в/в каждые 8 часов
Ципрофлоксацин - 500 мг в/в каждые
12 часов
Спектиномицин - 2,0 в/м каждые
12 часов.
Продолжительность терапии при всех схемах –7 дней
48.
ЛЕЧЕНИЕ БЕРЕМЕННЫХЛечение беременных осуществляется на любом сроке в
соответствии с установленным
диагнозом.
Препаратами выбора являются макролиды (эритромицин),
спектиномицин, некоторые цефалоспорины (цефтриаксон).
Рекомендуемая схема:
Цефтриаксон - 250 мг в/м однократно.
Противопоказаны тетрациклины, фторхинолоны,
аминогликозиды, левомицетин.
Альтернативная схема:
Спектиномицин - 2,0 г в/м однократно
49.
ЛЕЧЕНИЕ ГОНОКОККОВОЙ ИНФЕКЦИИ ГЛАЗРекомендуемая схема:
Цефтриаксон - 1,0 г в/м однократно
ЛЕЧЕНИЕ ОФТАЛЬМИИ НОВОРОЖДЕННЫХ
Рекомендуемые схемы:
Цефтриаксон - 25-50 мг/кг массы тела (не более 125 мг)
в/м или в/в однократно
Цефотаксим - 100 мг/кг массы тела в/м однократно
Местно:
раствор NaCl 0.9%
многократное промывание конъюнктивы
ПРОФИЛАКТИКА ОФТАЛЬМИИ НОВОРОЖДЕННЫХ
нитрат серебра - водный раствор 1 %
однократно по 2-З капли в каждый глаз
или
эритромициновая глазная мазь 0,5-1 % однократно
50.
ЛЕЧЕНИЕ ГОНОКОККОВОЙИНФЕКЦИИ У ДЕТЕЙ
Рекомендуемые схемы лечения
(при массе тела менее 45 кг.):
Цефтриаксон - 125 мг в/м однократно
Альтернативная схема:
Спектиномицин - 40 мг на 1 кг массы тела
не более 2,0 г в/м однократно
При массе тела более 45 кг
применяются схемы лечения для взрослых с
учётом противопоказаний к назначению препаратов.
СГМА
51.
ЛЕЧЕНИЕ ОСЛОЖНЕНИЙ НЕОНАТАЛЬНОЙГОНОКОККОВОЙ ИНФЕКЦИИ
Рекомендуемая схема лечения
Цефтриаксон - 25-50 мг на 1 кг массы тела в/м или
в/в 1 раз в сутки в течение 7 дней.
При менингите - не менее 10-14 дней
Альтернативная схема:
Цефотаксим - 25 мг на 1 кг массы тела в/м или
в/в каждые 12 часов в течение 7 дней.
При менингите - не менее 10-14 дней.
ПРОФИЛАКТИЧЕСКОЕ ЛЕЧЕНИЕ НОВОРОЖДЕННЫХ,
РОДИВШИХСЯ ОТ МАТЕРЕЙ, БОЛЬНЫХ ГОНОРЕЕЙ
Цефтриаксон - 25-50 мг на 1 кг массы тела
(не более 125 мг) в/м однократно

Медицина
Медицина








